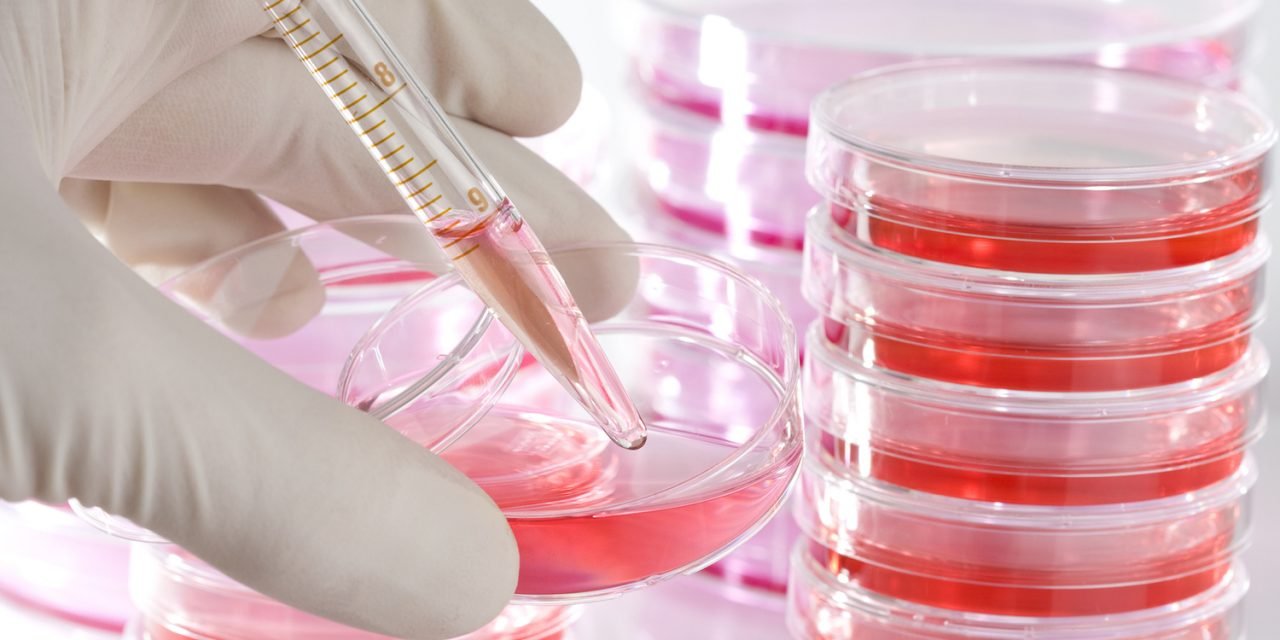
Nagalase en GcMAF

Nagalase en GcMAF
Een obscure thriller!
U bent begonnen te lezen omdat dit een hele vreemde titel is. Gelukkig maar omdat dit artikel misschien voor u een belangrijke betekenis heeft of zal krijgen.
Nobuto Yamamoto is een Japanse immunoloog die zijn werkterrein verlegde naar de Verenigde Staten. Van 1980 tot 1990 was hij hoogleraar Microbiologie & Immunologie aan de Hahnemann University School of Medicine in Philadelphia. Sinds zijn pensionering richtte hij zich als biochemisch onderzoeker aan de Temple University Medical School op kankertherapieën met Gc-MAF. Professor Yamamoto is de oprichter van het Socrates Institute for Therapeutic Immunologie.
Nobuto Yamamoto heeft in de Verenigde Staten ruim dertig jaar wetenschappelijk onderzoek gedaan naar macrofagen. De activiteit van deze witte bloedcellen, die bacteriën en tumorcellen (lichaamsvreemde cellen) kunnen opnemen, verteren en afvoeren, is bij kankerpatiënten onderdrukt. Yamamoto ontdekte dat toediening van Gc-MAF, een lichaamseigen stof, de activiteit van macrofagen met een factor 260 versterkt. Vandaar de afkorting Gc-MAF, wat staat voor ‘Gc protein-derived macrophage activating factor’. Yamamoto ontdekte bovendien Nagalase als belangrijke tumormarker. De hoeveelheid Nagalase in het bloed is een indicatie voor de hoeveelheid tumorweefsel.
Gc-MAF-methode
De door Yamamoto ontwikkelde Gc-MAF-methode is geschikt voor alle typen tumoren. Het meeste onderzoek is echter gedaan naar de toepassing van Gc-MAF bij borst- en prostaatkanker. Zo was van de 16 prostaatkankerpatiënten die Yamamoto behandelde, 100% binnen 14 tot 25 weken tumorvrij. Omdat de methode nog niet grootschalig getest is – daar zijn enorme bedragen mee gemoeid – is de behandeling nog experimenteel. Dat geldt voor meer innovatieve en immunologische behandelingen. In veel gevallen is er voor dergelijke behandelingen niet de tijd om te wachten tot het hele traject van patenteren, testen en checken is doorlopen. Gedurende 7 jaar controle na de Gc-MAF-therapie vertoonden de behandelde patiënten geen toename van Nagalase, de tumormarker in het bloed. Bovendien geeft de jaarlijkse controle via een lichaamsscan op tumoren aan dat de patiënten al 7 jaar tumorvrij zijn.
Nagalase
Tumorcellen hebben een heel ingenieus zelfbehoudmechanisme. Ze scheiden onder andere Nagalase uit, een enzym dat het immuunsysteem onderdrukt. Dit zorgt ervoor dat ze zelf niet opgeruimd worden. Gc-MAF is de stof die dit mechanisme doorbreekt. De Linus Pauling Kliniek, waaraan een professor in de immunologie, een arts en cellulair geneeskundigen zijn verbonden, maakte in 2008 kennis met de resultaten van Yamamoto’s onderzoek. De samenwerking tussen professor Yamamoto en de Linus Pauling Kliniek in Nederland maakt behandeling nu ook beschikbaar voor Europese patiënten. De therapie wordt begeleid door professor Yamamoto en zijn team. Het bloed van de patiënt wordt onderzocht bij Yamamoto zelf: in het Socrates Institute for Therapeutic Immunologie in Philadelphia.
De onderzoeken (Yamamoto 2006) hebben plaats gevonden bij kleine groepen patiënten met uitgezaaide borstkanker, prostaatkanker en darmkanker, die in goede conditie waren. Er is nog geen onderzoek geweest naar andere indicaties, maar op theoretische gronden moet het ook werken bij andere kankersoorten. Bij ernstige gevallen heeft het onvoldoende effect (waarschijnlijk doordat de tumorload te groot is voor het immuunsysteem om aan te vallen).
Gesloten
De GcMAF behandeling is door onderzoek bevestigd, maar nog niet algemeen aanvaard. In juni 2015 hebben bevoegde medische autoriteiten (Medicine and Healthcare Products Regulatory Agency – MHRA), in het Verenigd Koninkrijk de medische toezichthouder in het Verenigd Koninkrijk, een GcMAF laboratorium gesloten. Het laboratorium in kwestie behoort toe aan Immuno Biotech Ltd, een onderneming die de voorbije jaren agressief promotie voerde voor GcMAF en dit product online verkocht onder de merknaam First Immune. Naast het nu gesloten laboratorium heeft dit bedrijf nog medische centra in Zwitserland en Duitsland, waar heel wat aandoeningen met het product behandeld worden.
Obscuur
Maar het verhaal over Nagalase en GcMAF gaat verder en heeft een obscure wending genomen.
Het enzym Nagalase breekt de werking van GcMAF af. Dat enzym Nagalase wordt o.a. geproduceerd door kankercellen. Bij kleine kinderen zien we nog niet zo vaak kanker en toch zagen onderzoekers soms bij jonge kinderen zonder kanker hoge spiegels van Nagalase. Wel waren deze jonge kinderen al overvloedig gevaccineerd.
De onderzoekers die dit ontdekten verdwenen en kwamen op bedenkelijke wijze om het leven.
De eerste dood gevonden arts – Jeff Bradstreet overleed 19-6-2015 – ontdekte de link tussen vaccinaties, autisme en hoge spiegels van Nagalase. Hij behandelde deze kinderen met GcMAF dat hij uit Europa importeerde, hoewel dat illegaal was. Hierdoor verbeterde de immuunfunctie en knapten de meeste autisten op. Andere artsen volgden het voorbeeld van Dr. Bradstreet en moesten dit ook bekopen met de dood of verdwijning. Dr. Jeff Bradstreet zou zichzelf eerst in de borst hebben geschoten om zich vervolgens in de rivier te hebben geworpen.
Die kinderen zouden dan eigenlijk alleen die relatief grote hoeveelheid Nagalase kunnen hebben binnengekregen door vaccins. Op de website van een laboratorium voor bloedonderzoek (ELN-Bunnik) is het volgende te lezen:
“Nagalase is the intrinsic component of the envelope protein GP120 of HIV-virions and of the envelope protein hemagglutinin (HA) of influenza virus. Nagalase activity is the sum of enzyme activities carried by both HIV virions and unassembled envelope proteins.”
Misschien (als u alles goed doorleest en goed bijhoudt) kunt u zich herinneren dat in de periode van de vaccinaties tegen de pandemische varkensgriep (Mexicaanse griep H1N1) nogal wat was te doen over en geheimzinnig ingrediënt van Pandemrix, namelijk GP120. H1N1‐gevaccineerden testen (vals) positief op HIV, Hepatitis C en het Leukemie veroorzakende retrovirus HTLV dóór het H1N1‐vaccin, beter bekend als het Mexicaanse Griep‐vaccin!
Dit staat namelijk in de officiële bijsluiters van de H1N1‐vaccins:
“4.5 Interacties met andere geneesmiddelen en andere vormen van interactie[….] Deze voorbijgaande vals‐positieve resultaten zouden kunnen liggen aan een IgM‐kruisreactie door het vaccin.”
Inmiddels is de Engelstalige bijsluiter veranderd! Het H1N1-vaccin Pandemrix bevatte dus GP120 in daarom ook het intrinsieke Nagalase!
En omdat dit gegeven voor onrust zorgde werd het uit de bijsluiters verwijderd. Geen wonder dat Pandemrix voor zoveel nare bijwerkingen zorgde, ook op langere termijn.
Niet alleen aan Pandemrix werd GP120 – en daarmee Nagalase – toegevoegd, maar men experimenteert ook met diverse andere soorten vaccins.
Er is de maanden na de dood van een aantal holistische artsen in Amerika veel ophef geweest. Het lijkt een thriller maar naar nu blijkt, is de reden van al die moorden waarschijnlijk omdat deze artsen een vreselijk geheim hebben ontdekt en wel dat mensen via vaccinaties een gevaarlijk enzym binnenkrijgen.
Denk dus nog een keer na wanneer u de oproep ziet om u te laten vaccineren tegen de griep. Denk twee keer na en zeg NEEN!
![]()





















